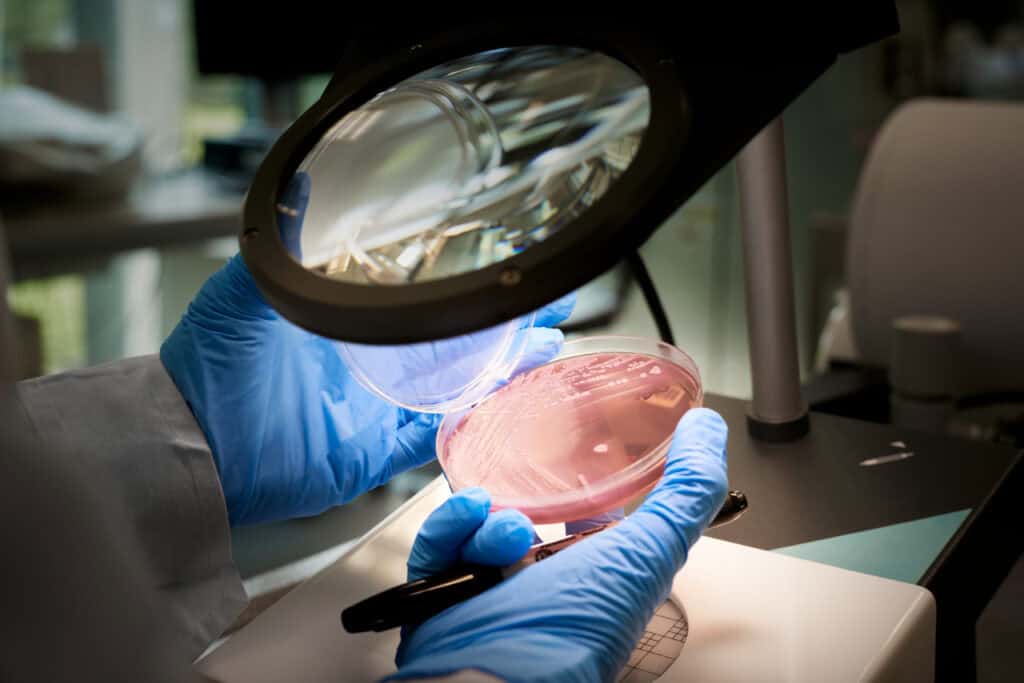

È in corso una trasformazione radicale nell’approccio alla cura del tumore: non più trattamenti standardizzati, ma terapie personalizzate, calibrate sul profilo genetico di ogni singolo paziente. E per questo si è costruita la prima piattaforma, in Italia, di Oncologia di precisione; l’Associazione per l’Oncologia di Precisione con presidente il professor Sergio Del Bianco del Centro Medico Affidea di Roma e con vicepresidente il professor Umberto Tirelli della Clinica Tirelli Medical di Pordenone.
Decodificare il tumore per colpirlo con precisione con l’Oncologia di Precisione

Il test analizza direttamente il DNA del tumore per individuare mutazioni genetiche specifiche, le cosiddette driver, che rappresentano i motori della crescita tumorale. Identificare queste alterazioni consente di selezionare farmaci mirati che agiscono con precisione sul bersaglio molecolare, offrendo: maggiore efficacia terapeutica; minore tossicità sistemica.
Del Bianco e Tirelli spiegno: “Questo approccio, noto come targeted therapy, è ormai standard nella gestione di molte neoplasie solide e oncoematologiche, ed è in continua evoluzione grazie ai progressi della genomica oncologica”.
Un breve incontro per una grande svolta terapeutica: ogni paziente potrà accedere a un colloquio individuale con un medico oncologo, che valuterà l’indicazione al test sulla base della storia clinica e del tipo di tumore. Un momento fondamentale per orientare correttamente la strategia terapeutica, in linea con i più aggiornati protocolli di medicina di precisione.
“È il tumore a parlare attraverso il suo profilo genetico. Il nostro compito è ascoltarlo e colpirlo con precisione”, spiegano i due oncologi.
Accessibilità e criteri clinici
Il test è disponibile, in alcune aree del territorio nazionale, nell’ambito di percorsi regolati da protocolli regionali o iniziative sanitarie dedicate, attivati sulla base di specifici requisiti clinici e organizzativi.
Tali percorsi, laddove attivi, possono prevedere modalità di accesso agevolate per il paziente, in relazione al quadro normativo e regolatorio locale. In alternativa, il test può essere richiesto attraverso soluzioni personalizzate, sostenute da programmi integrati di supporto, sempre nel rispetto dei criteri di appropriatezza clinica e su indicazione del medico oncologo.
Con questa iniziativa, l’A.O.P. insieme a TomaLab (il Laboratorio di genetica collegato con l’Università di Milano), e Onco Precision, mirano a portare la medicina del futuro nel presente, rendendo concretamente accessibile un’oncologia di precisione fondata sull’evidenza molecolare e sulla centralità del paziente.







































































